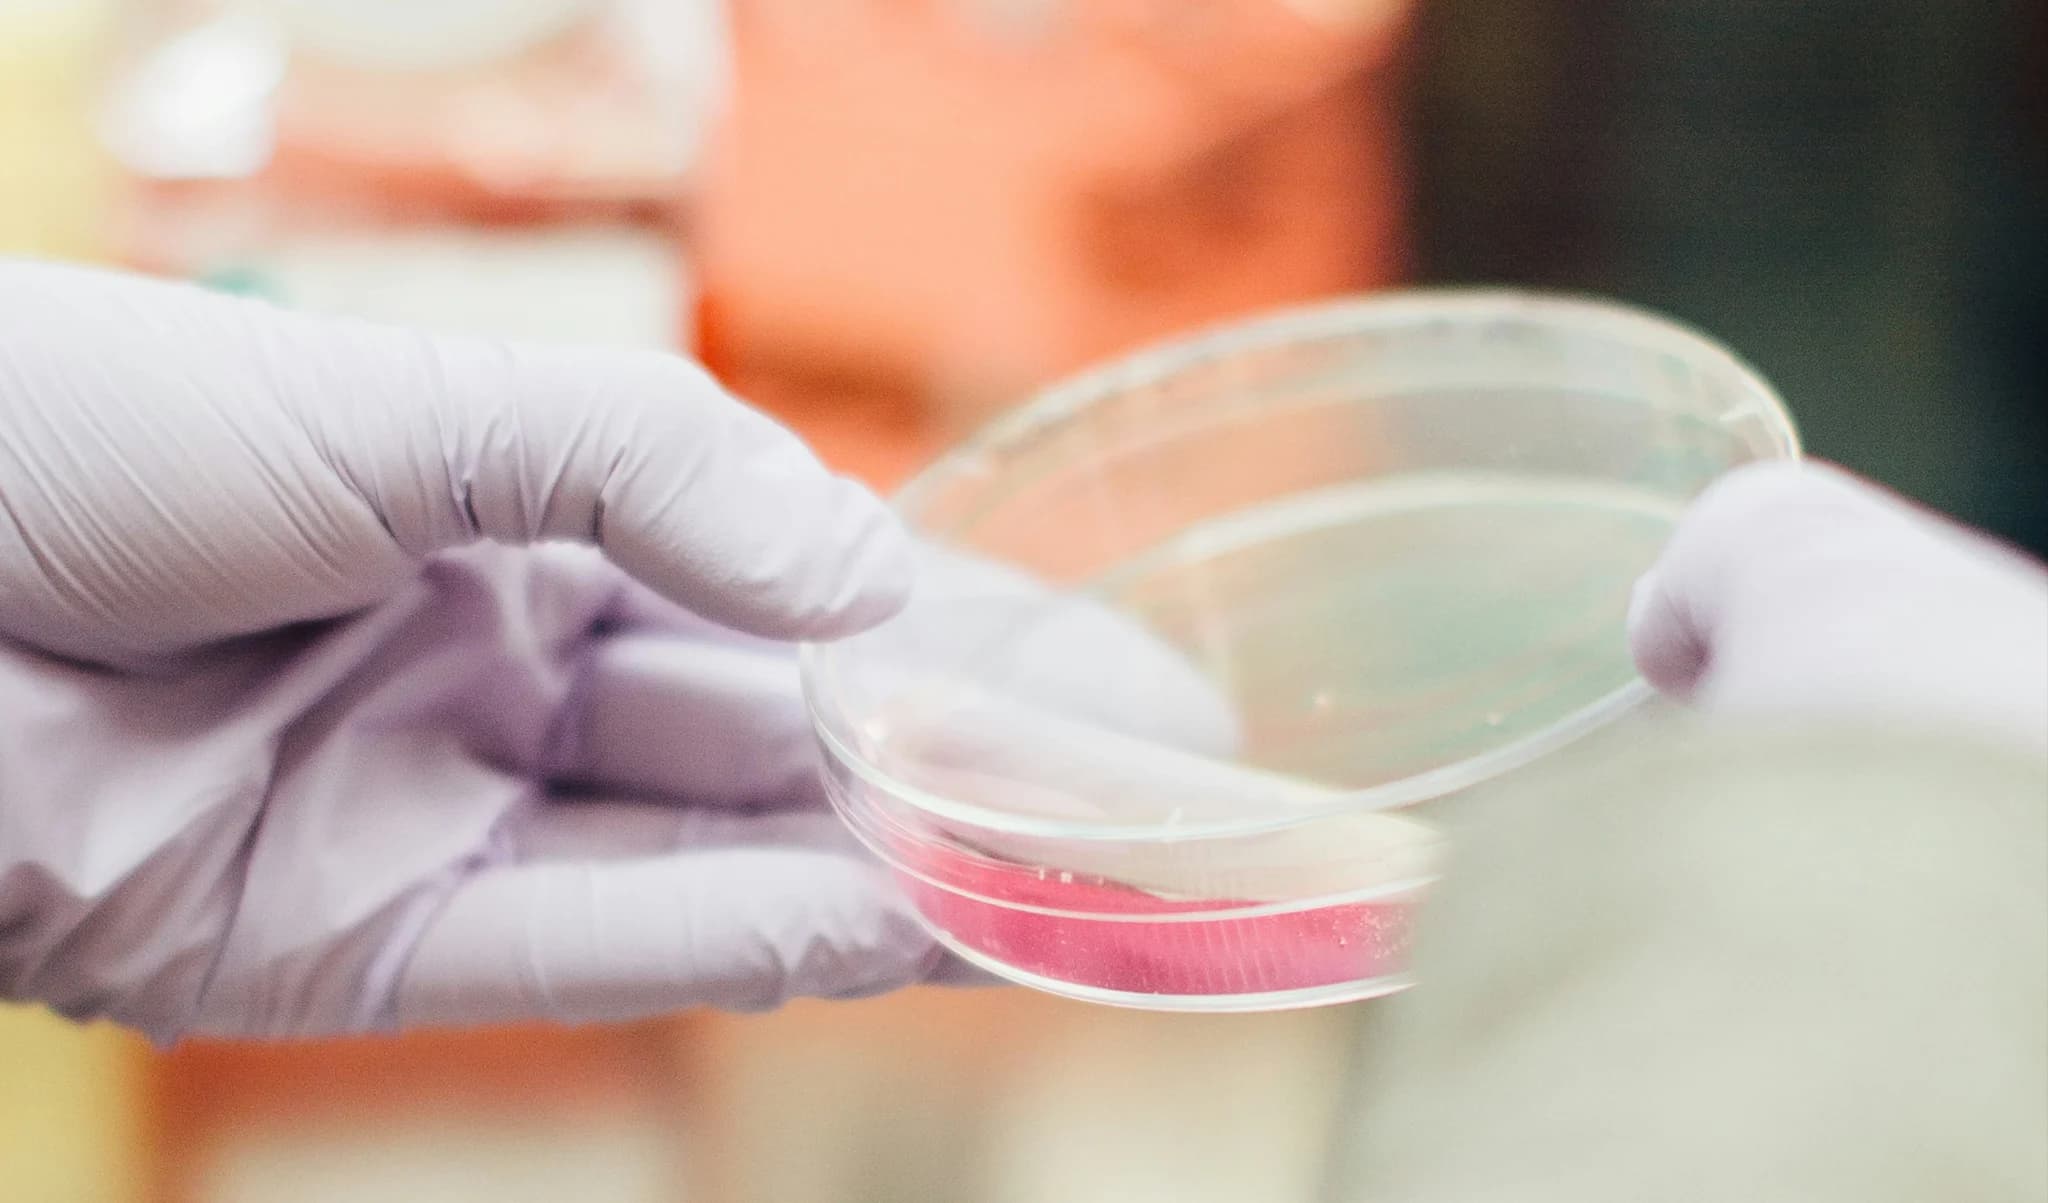

Founded in Sweden, Lithea was created to change how solid cancer tumours are treated. We're creating the next generation of cancer therapy, starting with bone cancer.

Chief Executive Officer
Ludvig Sjöberg has over 10 years’ experience in life science across R&D and commercial roles. He was most recently CEO of a medtech company in organ transplantation and has also worked with Igelösa Life Science and Vivoline Medical. He brings expertise in business development, leadership, and cross-sector collaboration. Ludvig holds a B.Sc. in Mechanical and Material Engineering with additional studies in management.

Chief Medical Officer
With over 10 years of international medical experience, Mathias has worked in the UK, Switzerland, and Sweden. He is a board-certified clinical geneticist and has served as a registrar in oncology at Skåne University Hospital and Addenbrooke’s Hospital in Cambridge. He holds a medical degree from the University of Cambridge and a Ph.D. in health economics from Karolinska Institute.

Chief Financial Officer
Åke Knutsson, MBA, has extensive experience as CEO and CFO in companies like Biomet Cementing Technologies, A Clean Partner International, Prestando Group, Safeture and Curando Nordic. Several of these are global and listed companies.

Chief Technical Officer
Deepak conducts ongoing research at Lund University in biomaterials and targeted drug delivery for cancer, infection, and bone healing. He has published widely in scientific journals and received several nominations for the New Investigator Recognition Award from the Orthopedic Research Society. In 2022, he was a finalist among promising entrepreneurs in Southern Sweden. Deepak holds a Ph.D. from the Faculty of Medicine, Lund University.

Director Design & Development
Anna is a skilled R&D professional with broad experience in the medical device and pharmaceutical industry. Before joining Lithea, she was Product and Process Support Manager at the listed company Immunovia AB. She has also held roles at Johnson & Johnson, Baxter International, and Gambro AB, further building her expertise. Anna holds a Ph.D. in Biochemistry from Lund University.

Director Manufacturing & Supply
Linda has over 18 years of experience in R&D, production, and product development. Before joining Lithea, she held key roles at listed companies including Genovis AB and GE Healthcare. As former Vice President Production, she led production and quality control teams while contributing to product development. Linda holds an M.Sc. in Chemistry from Lund University.

Senior advisor
Lindberg is an MD, PhD and has previously held positions as the Department Head at the Department of Clinical Pharmacology, Lund University Hospital, Nordic Medical Director at Searle Pharmaceuticals, Co-founder and CEO of BoneSupport AB, CEO of Enzymatica AB, and CEO of AGB Pharma AB. Fredrik is currently the CEO of Moroxite AB.

Head Quality Management and Regulatory Affairs
Carin has over 40 years’ experience in the global healthcare and medical device industry, with a focus on quality and regulatory compliance for medical devices and combination products. She has worked at Gambro AB and Bonesupport AB, and now acts as an independent consultant in regulatory and quality. Carin holds an M.Sc. in Chemical Engineering from Lund University.

Chairman of the Board
Semmy Rülf, Dr. h.c, M.Econ, has an extensive experience in the life science and IT industries. As a CEO, he built up the successful IT company Axis Communications and the medtech company ProstaLund. He was the Regional Director at VisitSweden in London. Board member at Qliktech and Safeture. Chaired many successful companies in the Life Science field like BoneSupport (publ.), Dignitana (publ.), Vitrolife (publ.), Xvivo Perfusion (publ.), and Jolife. Currently Chairman of the Board of Moroxite F, UGLK Science, and UGLL Research, and Senior Advisor at Igelösa Life Science.

Board member
Engellau is an MD, PhD, and an associate clinical professor at the Department of Oncology, Lund University. He has extensive experience in bone and soft tissue tumor treatment and has developed a system for the prognostication of soft tissue sarcomas. He has also experience in the biotech industry and previously for 8 years was a board member of Genovis AB.

Board member
Kristina Tägil, MD, PhD, has been working for 20 years at the interface between healthcare and technology and during the years founded several companies in the digital health sector. The refinement of healthcare using the new technology has been the beacon in her career and has continued to contribute by acting as an advisor and mentor for start-up companies. Kristina currently works as a Lead Physician Executive at Cerner AB, a global company that develops digital ecosystems in healthcare.

Board member
Jostein has more than 35 years of International Pharma Leadership Experience. He held during his career several Leading International Management Positions at Nycomed before the company was acquired by Takeda Pharmaceuticals in 2011. Jostein then became a Corporate Officer at Takeda and a member of the Executive Commercial Management Team as the Head of Global Emerging Markets. Later on he was the CEO of the Swiss based company Acino Pharmaceuticals. Jostein has been serving as a management coach for leaders within the pharma industry. Today he holds several Board mandates and advisory roles within the industry. Jostein studied Business and Administration at the Oslo School of Economics, and has completed several Leadership programs at IMD Switzerland and holds an IMD Board Directors Diploma.

Chief Medical Officer
With over 10 years of international medical experience, Mathias has worked in the UK, Switzerland, and Sweden. He is a board-certified clinical geneticist and has served as a registrar in oncology at Skåne University Hospital and Addenbrooke’s Hospital in Cambridge. He holds a medical degree from the University of Cambridge and a Ph.D. in health economics from Karolinska Institute.